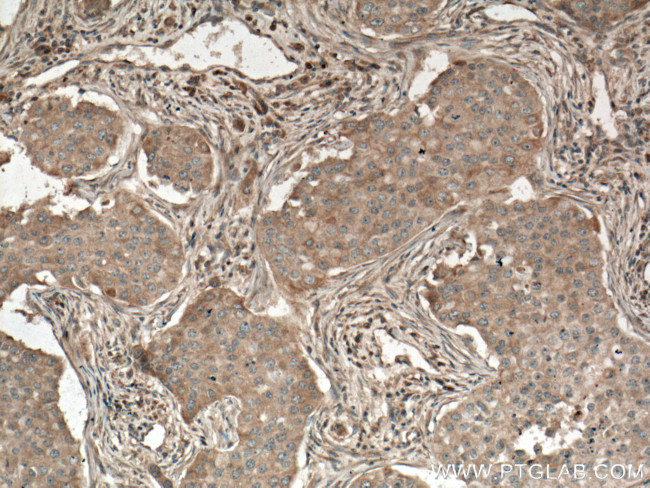
PLCB3 Antibody in Immunohistochemistry (Paraffin) (IHC (P))
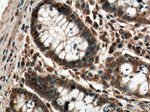
PLCB3 Antibody in Immunohistochemistry (Paraffin) (IHC (P))

Search
Proteintech
PLCB3 Monoclonal Antibody (1B8B3)
{{$productOrderCtrl.translations['antibody.pdp.commerceCard.promotion.promotions']}}
{{$productOrderCtrl.translations['antibody.pdp.commerceCard.promotion.viewpromo']}}
{{$productOrderCtrl.translations['antibody.pdp.commerceCard.promotion.promocode']}}: {{promo.promoCode}} {{promo.promoTitle}} {{promo.promoDescription}}. {{$productOrderCtrl.translations['antibody.pdp.commerceCard.promotion.learnmore']}}
产品信息
66668-1-IG
种属反应
宿主/亚型
分类
类型
克隆号
抗原
偶联物
形式
浓度
纯化类型
保存液
内含物
保存条件
运输条件
产品详细信息
Immunogen sequence: AQAGQETCQ DTQSQQLGSQ PSSNPTPSPL DASPRRPPGP TTSPASTSLS SPGQRDDLIA SILSEVAPTP LDELRGHKAL VKLRSRQERD LRELRKKHQR KAVTLTRRLL DGLAQAQAEG RCRLRPGALG GAADVEDTKE GEDEAKRYQE FQNRQVQSLL ELREAQVDAE AQRRLEHLRQ ALQRLREVVL DANTTQFKRL KEMNEREKKE LQKILDRKRH NSISEAKMRD KHKKEAELTE INRRHITESV NSIRRLEEAQ KQRHDRLVAG QQQVLQQLAE EEPKLLAQLA QECQEQRARL PQEIRRSLLG EMPEGLGDGP LVACASNGHA PGSSGHLSGA DSESQEENTQ L (885-1234 aa encoded by BC142681)
靶标信息
PLCB3 encodes a member of the phosphoinositide phospholipase C beta enzyme family that catalyze the production of the secondary messengers diacylglycerol and inositol 1,4,5-triphosphate from phosphatidylinositol in G-protein-linked receptor-mediated signal transduction. Alternative splicing results in multiple transcript variants.
仅用于科研。不用于诊断过程。未经明确授权不得转售。
生物信息学
蛋白别名: 1-phosphatidylinositol 4,5-bisphosphate phosphodiesterase beta-3; 1-phosphatidylinositol-4,5-bisphosphate phosphodiesterase beta-3; EC 3.1.4.11; Phosphoinositide phospholipase C-beta-3; phosphoinositide-specific phospholipase c; phospholipase C beta 3; phospholipase C, beta 3 (phosphatidylinositol-specific); Phospholipase C-beta-3; PLC beta 3; PLC-beta-3; PLC-beta3; PLCbeta3
基因别名: mKIAA4098; PLCB3
UniProt ID: (Human) Q01970, (Mouse) P51432
Entrez Gene ID: (Human) 5331, (Rat) 29322, (Mouse) 18797